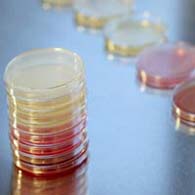

Sehr geehrte Kolleginnen und Kollegen,
die Deutsche Menopause Gesellschaft e.V. kümmert sich um das Wohlbefinden und die Gesundheit der Frau im Klimakterium und der Postmenopause.
Sie möchte sowohl für Fachkreise als auch für Frauen Ansprechpartner für diesen wichtigen Abschnitt im Leben einer Frau sein.
Dabei legt sie besonderen Wert auf die wissenschaftliche Bearbeitung der Fragestellungen, die sich fachübergreifend aus zahlreichen Bereichen (z.B. Diabetologie, Ernährungswissenschaft, Innere Medizin, Kardiologie, Onkologie, Ophthalmologie, Osteologie, Neurologie, Psychiatrie, Psychologie, Epidemiologie, etc.) ergeben und auf die Förderung des interdisziplinären Dialoges.
Besonders am Herzen liegen uns junge Forscherinnen und Forscher.
Ihnen möchten wir eine Plattform bieten, in einer kollegialen Atmosphäre Erfahrungen in Präsentation und Diskussion wissenschaftlicher Arbeiten zu erlangen.
Mit dieser Webseite möchten wir Sie als junge wie auch als erfahrene Wissenschaftler*In ansprechen, Ihnen den Wissenschaftspreis der Deutschen Menopause Gesellschaft e.V. „Neues aus der Wissenschaft“ vorstellen und Sie auffordern, Ihre Arbeit hier in einem fachkundigen Kreis vorzustellen, miteinander zu diskutieren und gegenseitig voneinander zu profitieren.
Wir würden uns sehr freuen, Sie in der Session “ Neues aus der Wissenschaft“ begrüßen zu können.
Diese wird regelmäßig zu Beginn unserer jährlichen, im November in Frankfurt stattfindenden Jahrestagung, durchgeführt.
Mit kollegialen Grüßen
Dr.med. Katrin Schaudig
Präsidentin Deutsche Menopause Gesellschaft